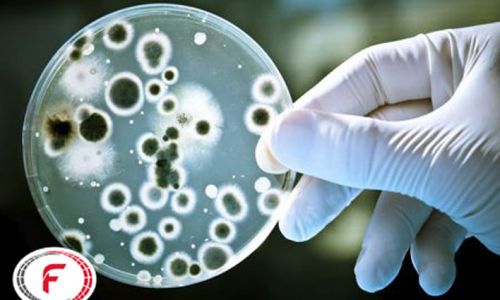

شرح فعالیت ایمن محیط

شرکت ایمن محیط
شرکت ایمن محیط اولین شرکت خصوصی در سطح کشور در مهرماه سال 1363 تحت شماره 53720 ثبت و پس از اخذ مجوزات لازم وتامین تجهیزات فنی و نیروی انسانی متخصص تاسیس و در همین محل فعلی به فعالیت خود در زمینه های بازرگانی ، خدمات HSE (مهندسی ایمنی ، بهداشت و محیط زیست ) و همزمان با تاسیس واحد طب کار و کلینیک ادیومتری و اسپیرومتری به انجام فعالیت در امور مذکور مشغول بکار گردید ( از سال 67 بدلیل عدم وجود اداره طب کار در وزارت بهداشت و عدم شناخت این رشته در بخش خصوصی و وجود اختلافات اداری و فنی بین معاونت های بهداشت و درمان در وزارت بهداری وقت در امور نظارتی بر فعالیت های طب کار در بخش خصوصی ناچارا این شرکت واحد خدمات طب کار خود را پس از 3 سال تعطیل کرد ) و بهسایر خدمات فنی و بازرگانی در بخش HSE خود براساس مجوزات موجود و اساسنامه و مقررات جاری با انجام تامین تجهیزات تخصصی بهداشت حرفه ای و فروش و تعمیرات و کالیبراسیون تجهیزات HSE از سال 80 و سنجش آلاینده های محیط کار و محیط زیست بااخذ مجوز از معاونت بهداشت دانشگاه علوم پزشکی ایران و سازمان حفاظت محیط زیست به فعالیت خود ادامه می دهد و جهت استحضار رئوس بخش هایی از خدمات ارائه شده از سال 1363 تاکنون را که در سوابق خود دارد بشرح ذیل اعلام میدارد :
1- انجام معاینات دوره ای و استخدامی اودیمتری واسپیرومتری برای بیش از 12000 شاغل و در جریان استخدام ( حدفاصل 64 تا 67 )
2- انجام طرح های بهسازی در بخش بهداشت صنعتی
3- آموزش مشاورات فنی ، ایمنی و بهداشت کار و تشکیل سیستم های حفاظت و بهداشت کار در بیش از 200 کارگاه و کارخانه
4- واردات و تامین و فوش و تعمیرات و کالیبراسیون تجهیزات تخصصی بهداشت حرفه ای و لوازم و تجهیزات HSE
5- انجام سمپاشی محیط کار و مبارزه باحشرات موذی در صنایع و کارگاه ها ( از سال 65 تا سال 1390 )
6- طراحی ، ثبت اختراع و تولید و اجرای سیستم لوله کشی مایع دستشویی در سرویس های بهداشتی اماکن عمومی و کارگاه ها
7- طراحی و اجرای سیستم های تصفیه آب و پساب
8- طراحی و اجرای سیستم های ارتینگ و تست های دوره ای چاه های ارت
9- نمونه برداری و آلاینده سنجی محیط کار و محیط زیست از سال 1380 تاکنون
10- ارزیابی و کارشناسی و مشاوره ایمنی و حوادث ناشی از کار
11- انجام کارشناسی و ارزیابی ریسک فاکتورهای بالقوه در صنایع و کارگاه ها و ارائه طریق برای پیشگیری و رفع آن